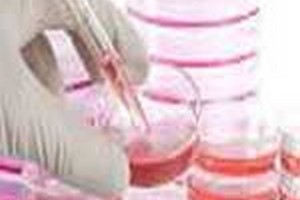
دروس وضرایب بیوشیمی بالینی دروس امتحانی وضرایب درسی بیوشیمی بالینی

دروس امتحانی وضرایب درسی بیوشیمی بالینی
بیوشیمی بالینی (6) بیولوژی سلولی مولکولی (2) شیمی آلی و عمومی (2) زبان عمومی (3)
مطالب مرتبط:
کارنامه رتبه های برتر آزمون ارشد بیوشیمی بالینی
دانلود سوالات آزمون بیوشیمی بالینی
کلاس کنکور کارشناسی ارشد بيوشيمی بالينی
جزوات نفرات برتر کارشناسی ارشد بيوشيمی بالينی
آزمون های کشوری کارشناسی ارشد بیوشیمی بالينی
درباره رشته کارشناسی ارشد بیوشیمی بالينی
کلاس کنکور کارشناسی ارشد شیمی آلی (نمایش ویدئویی)
کلاس کنکور کارشناسی ارشد بیوشیمی بالینی (نمایش ویدئویی)
طرح درس کارشناسی ارشد بیوشیمی بالینی
منایع کنکور کارشناسی ارشد بیوشیمی بالینی
